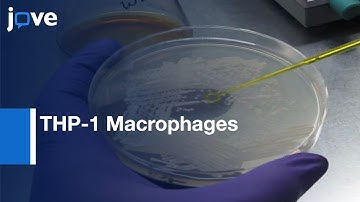

⬇ DOWNLOAD NOW
Kalau muncul iklan pop-up, tutup lalu klik tombol kembali
Download lagu Nucleofection for Efficient Transfection of Human THP-1 Macrophages | Protocol Preview secara gratis hanya untuk keperluan promosi. Dukung artis favorit kamu dengan membeli musik original di iTunes atau platform resmi lainnya.
 Highly Efficient Transfection of Human THP 1 Macrophages
Highly Efficient Transfection of Human THP 1 Macrophages
THP-1 Macrophages Intracellular Behaviour Study | Protocol Preview
THP-1 Macrophages Intracellular Behaviour Study | Protocol Preview
 Nucleofection technique
Nucleofection technique
 Macrophage engulfs foreign cells
Macrophage engulfs foreign cells
 Nucleofection Trouble Shooting Part 1
Nucleofection Trouble Shooting Part 1
 Introduction to Cell Transfection: Part 1
Introduction to Cell Transfection: Part 1
 Plasmid DNA Transfection Protocol
Plasmid DNA Transfection Protocol
 Macrophages THP1
Macrophages THP1